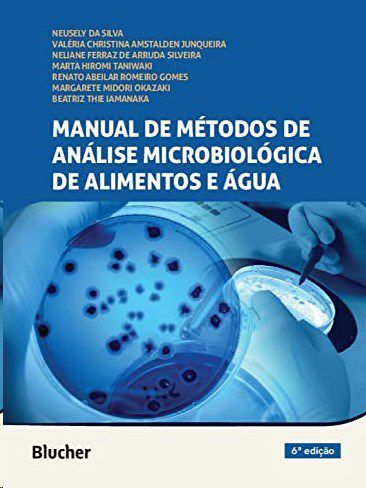
Livro Manual de Métodos de Análise Microbiológica de Alimentos e Água

Livro Manual de Métodos de Análise Microbiológica de Alimentos e Água
-
- 1x de R$ 297,00 sem juros
- 2x de R$ 148,50 sem juros
- 3x de R$ 99,00 sem juros
- 4x de R$ 74,25 sem juros
- 5x de R$ 59,40 sem juros
- 6x de R$ 49,50 sem juros
- 7x de R$ 42,42 sem juros
- 8x de R$ 37,12 sem juros
- 9x de R$ 33,00 sem juros
- 10x de R$ 29,70 sem juros
- 11x de R$ 27,00 sem juros
- 12x de R$ 24,75 sem juros
-
- 1x de R$ 297,00 sem juros
- 2x de R$ 162,82
- 3x de R$ 110,12
- 4x de R$ 82,68
- 5x de R$ 67,90
- 6x de R$ 56,59
- 7x de R$ 49,52
- 8x de R$ 43,34
- 9x de R$ 39,50
- 10x de R$ 35,83
- 11x de R$ 32,58
- 12x de R$ 30,22
-
R$ 282,15

:
ISBN 9786555062977
Edição 6
Ano 2017
Idioma Português
Autor Silva/junqueira/silv
Páginas 602
Encadernação Brochura
Sinopse:
O Manual de métodos de análise microbiológica de alimentos e água é um manual de laboratório ilustrado contendo os métodos recomendados por órgãos internacionais (APHA, FDA, USDA, AOAC, ISO) aceitos pela Agência Nacional de Vigilância Sanitária (ANVISA).Cada capítulo traz uma revisão profunda e atualizada sobre o(s) microrganismo(s) tratado(s), incluindo posição taxonômica, mudanças na nomenclatura, características morfológicas e bioquímicas e epidemiologia. Oferece também comparações esquemáticas entre os métodos disponíveis, destacando suas diferenças e similaridades. A apresentação didática do passo a passo dos métodos em figuras esquemáticas permite uma rápida apreensão dos procedimentos, facilitando sua execução no dia a dia dos laboratórios.
Produtos relacionados
-
 Livro Manual de Metodos de Analise Microbiologica de Alimentos e Agua - Silva/junqueira/silvR$ 308,00até 12x de R$ 25,66 sem jurosou R$ 292,60 via Boleto Bancário
Livro Manual de Metodos de Analise Microbiologica de Alimentos e Agua - Silva/junqueira/silvR$ 308,00até 12x de R$ 25,66 sem jurosou R$ 292,60 via Boleto Bancário -
 Livro Microbiologia dos Alimentos FrancoR$ 188,00até 9x de R$ 20,88 sem jurosou R$ 178,60 via Boleto Bancário
Livro Microbiologia dos Alimentos FrancoR$ 188,00até 9x de R$ 20,88 sem jurosou R$ 178,60 via Boleto Bancário -
 Livro Microbiologia da Segurança dos Alimentos - Forsythe - ArtmedR$ 176,00até 8x de R$ 22,00 sem jurosou R$ 167,20 via Boleto Bancário
Livro Microbiologia da Segurança dos Alimentos - Forsythe - ArtmedR$ 176,00até 8x de R$ 22,00 sem jurosou R$ 167,20 via Boleto Bancário -
 Livro Microbiologia de Alimentos Fermentados - Martin - BlucherR$ 319,00até 12x de R$ 26,58 sem jurosou R$ 303,05 via Boleto Bancário
Livro Microbiologia de Alimentos Fermentados - Martin - BlucherR$ 319,00até 12x de R$ 26,58 sem jurosou R$ 303,05 via Boleto Bancário
-
A Livro Pro é uma livraria especializada em livros técnicos e didáticos, com atuação focada nas áreas da saúde, direito, ciências humanas e ciências exatas. Nosso catálogo é cuidadosamente selecionado para atender às necessidades de estudantes, professores, pesquisadores e profissionais, oferecendo obras atualizadas, reconhecidas academicamente e alinhadas às exigências do mercado e da formação educacional. Trabalhamos com conteúdos que apoiam a graduação e pós-graduação até a atualização profissional!